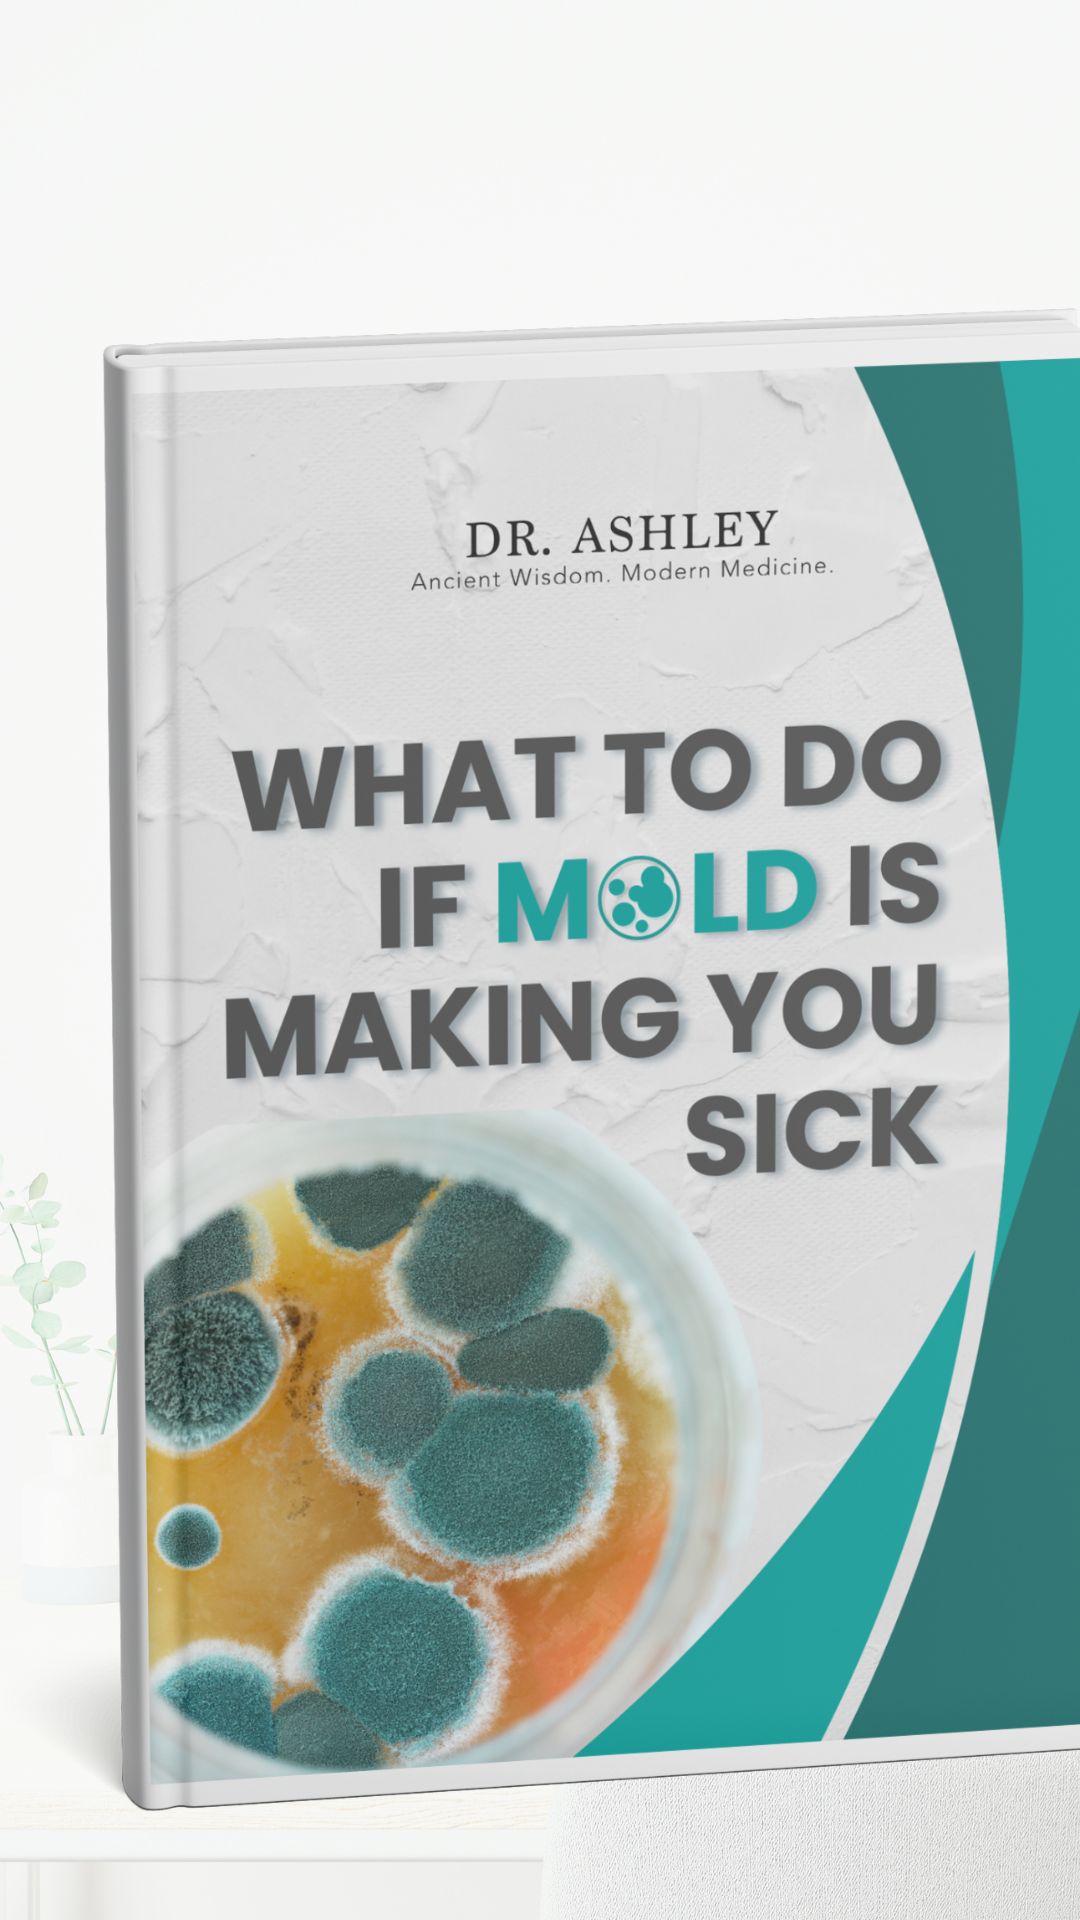

What to Do If Mold is Making You Sick
Download "What to Do If Mold is Making You Sick," where immediate action plans make way for comprehensive and adaptable strategies tailored to safeguard your health. Whether you're trying to identify the signs of mold exposure or need step-by-step guidance on how to handle a mold situation, this guide is your essential resource.
From initial symptoms to professional mold remediation, this guide offers a variety of insights and actionable steps each week, including how to document your symptoms, the importance of hiring a professional for mold inspection, and methods for ensuring long-term mold prevention. Each section is designed to be informative, allowing you to understand the severity of mold exposure and the best practices for addressing it effectively.
Dive into a world of crucial, health-saving measures that won’t just address the mold issues but will also help prevent future occurrences. Enjoy learning about the comprehensive strategies that make managing a mold-free environment simple and straightforward!